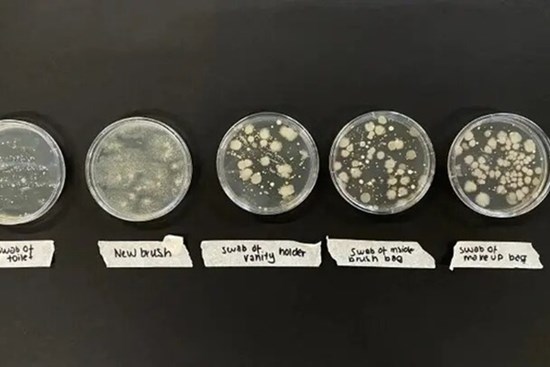
Cọ trang điểm bẩn như thế nào?

Chủ đề
trang điểm
Trang điểm có thể ảnh hưởng đến da thế nào?
Trang điểm giúp bạn trở nên xinh đẹp nhưng thực chất lại gây ra không ít tác hại cho làn da.
Mẹo thoa son căng mọng không cần tiêm filler
Sở hữu một đôi môi căng mọng sẽ giúp khuôn mặt bạn trở nên thu hút, quyến rũ ngọt ngào.
Cách dùng một thỏi son trang điểm cả gương mặt
Không cần đến cả bộ mỹ phẩm trang điểm đắt tiền, chỉ với một cây son cũng có thể khiến bạn trở nên xinh đẹp. Xem nhanh
Bí quyết trang điểm không bị lem ngày hè
Để bảo vệ lớp trang điểm không bị lem vào ngày hè nóng bức, các cô gái nên áp dụng ngay những bí quyết này.
Sai lầm trang điểm khiến chị em cộng thêm chục tuổi
Một vài lỗi trang điểm phổ biến mà rất nhiều phụ nữ mắc phải có thể khiến khuôn mặt bạn trông già đi và kém xinh. Những lỗi trang điểm gây lão hóa này có thể làm nổi bật các nếp nhăn và khiến bạn trông già hơn ngay lập tức.
Mẹo trang điểm mắt tiết kiệm mỹ phẩm
Bạn có thể tiết kiệm được khoản tiền lớn nếu biết các mẹo trang điểm dưới đây.
AGE20’S cùng dàn Tiktoker ‘ngược dòng’ tìm nét son Việt
Với thông điệp yêu thương và trân quý bản thân, tự tin khoe nét son riêng của mình ra thế giới, chiến dịch “Son” của nhãn hàng AGE020’S đã tạo thiện cảm với đông đảo công chúng.
Chàng trai Nhật Bản bị tố ‘mạo danh’ vì trang điểm quá giỏi
Nhờ khả năng trang điểm, Hatenyan gây ấn tượng, thu hút nhiều lượt theo dõi trên mạng khi chia sẻ các hình ảnh trước và sau khi phủ lớp make-up.
Các kiểu trang điểm khi mặc áo dài giúp bạn đẹp không tì vết
Trang điểm khéo léo, tinh tế sẽ giúp bạn trở thành một “nàng thơ” e ấp, cuốn hút trong tà áo dài.
7 bước trang điểm mùa hè cho da dầu nhờn cực hiệu quả
Thực tế rằng bất kì loại da nào cũng có thể trang điểm được kể cả làn da nhờn nhiều dầu nếu các nàng hiểu rõ loại da của mình.
Cọ trang điểm bẩn như thế nào?
Cọ trang điểm bạn đang dùng có thể rất bẩn, theo nhiều nghiên cứu, đây là nơi chứa lượng vi khuẩn khủng khiếp tích tụ.
Cái chết của kem nền
Khi ngày càng nhiều người chấp nhận và yêu bản thân hơn, kem nền cùng các sản phẩm che khuyết điểm dần bị loại bỏ.
Phụ nữ dù có làn da đẹp đến đâu cũng đừng mắc phải 3 thói quen trang điểm, vừa bị chê cười, vừa hại da
Thói quen hàng ngày trong trang điểm có thể gây nên cho bạn những ảnh hưởng xấu đến sức khỏe vô cùng nghiêm trọng. Nếu không muốn da mặt của bạn gặp phải vấn đề như kích ứng, nhiễm trùng... thì hãy dừng ngay những thói quen dưới đây.
Nhân viên tiệm spa phát "buồn nôn" khi nhìn thấy cảnh tượng trên mi mắt khách, dân mạng xem xong cũng tá hỏa
Đó là hỗn hợp của một loạt những thứ như phấn trang điểm, chất nhờn gì đó và cả bụi bẩn. Chúng hòa quyện với nhau và bám chặt trên mí mắt của người phụ nữ, làm cho mí mắt bị sưng đỏ.
Bắt trend trang điểm mùa thu với mốt kẻ mắt mèo, môi đỏ tía
Dưới đây là những xu hướng trang điểm được dự đoán sẽ phủ sóng mạng xã hội và các sàn runway trong mùa thu năm nay.
"Phù thuỷ" trang điểm cho Hoa hậu Đặng Thu Thảo và Nhã Phương, đột ngột qua đời, Mai Phương Thúy cùng dàn sao Việt bàng hoàng
Thông tin chuyên gia trang điểm Phan Minh Lộc (người từng làm việc với cả dàn sao nổi tiếng như Hoa hậu Đặng Thu Thảo, Nhã Phương, Minh Hằng, Hoàng Thùy Linh, Đông Nhi) qua đời đã khiến nhiều sao Việt vô cùng xót xa và bàng hoàng.
Đây chính là lý do vì sao tô hẳn son đắt tiền mà da dẻ cứ thâm sạm, nhan sắc không sang nổi
Nếu không chọn đúng sắc son phù hợp nhan sắc chỉ có đường tuột dốc không phanh.
4 điều "tối kị" khi make up mà các nàng có thể học ngay từ phim Hàn: Đừng để năm mới đến mà mặt mũi trông như hề
Ngay từ tập đầu tiên, nữ chính đã cho thấy màn make up "cường điệu" với cả loạt lỗi sai mà chị em cần ghim ngay lập tức.
Chuyện về người phụ nữ làm nghề trang điểm tử thi ở Việt Nam: "Tôi bị rất nhiều người kì thị, giấu cả gia đình để làm"
Từ bỏ công việc makeup chuyên nghiệp, thu nhập ổn định, chị Loan chuyển sang làm nghề trang điểm cho người đã mất. Công việc khi nói ra khiến nhiều người sợ hãi, bản thân chị cũng bị kì thị nhiều.